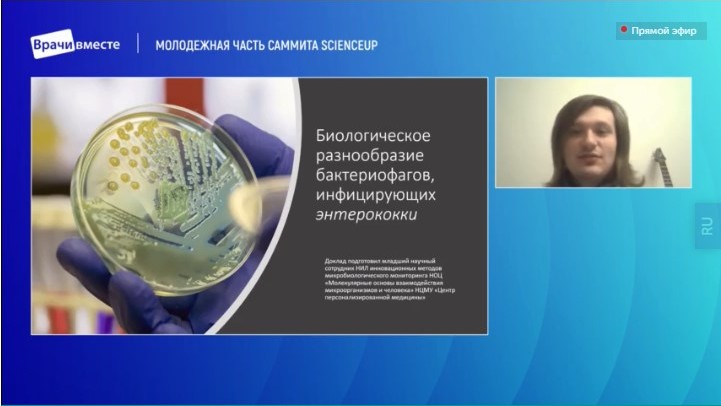

Интеграционный саммит «Научные центры мирового уровня в сфере здравоохранения» в онлайн-формате проходил с 30 ноября по 1 декабря 2021 года и был приурочен к «Году Науки и Технологий».
Саммит организован при взаимодействии НЦМУ «Центр персонализированной медицины», НЦМУ «Цифровой биодизайн и персонализированное здравоохранение», НЦМУ «Национальный центр персонализированной медицины эндокринных заболеваний», НЦМУ «Павловский центр «Интегративная физиология — медицине, высокотехнологичному здравоохранению и технологиям стрессоустойчивости».
Мероприятие проходило при поддержке Правительства Российской Федерации, Министерства науки и высшего образования РФ, Министерства Здравоохранения РФ и Российской академии наук.
Цели Саммита — обмен опытом, демонстрация достижений, обсуждение перспектив сотрудничества и интеграции НЦМУ, эффективное использование интеграционных ресурсов Сеченовского университета, создание единой системы подготовки новых кадров для медицины будущего в условиях цифровизации экономики. Основными темами обсуждения специалистов в рамках мероприятия стали онкология; инфекционные заболевания; кардиология; физиология — медицине; цифровые экосистемы и искусственный интеллект в медицине; неврология и нейродегенерация; генетика и редкие заболевания; эндокринология и патология метаболизма.
Председатель Саммита ректор Первого Московского государственного медицинского университета им. И.М. Сеченова, академик РАН Петр Витальевич Глыбочко. В качестве сопредседателей выступили генеральный директор ФГБУ «Национальный медицинский исследовательский центр имени В. А. Алмазова» Минздрава России, академик РАН Евгений Владимирович Шляхто; директор ФГБУ «Национальный медицинский исследовательский центр эндокринологии» Министерства здравоохранения РФ Наталья Георгиевна Мокрышева; директор Института физиологии имени И. П. Павлова Людмила Павловна Филаретова.
В своем выступлении Е. В Шляхто сказал:
«Хочу отметить чрезвычайную важность саммита. Трудно переоценить значимость этого события, поскольку вопросы интеграции, межведомственного взаимодействия сегодня являются критически важными для создания, развития и главное — использования в реальной клинической практике достижений науки.
Основной задачей Научного Центра мирового уровня «Центр персонализированной медицины», включающий в себя Центр Алмазова и Институт экспериментальной медицины, является создание биомедицинской экосистемы для разработки и внедрения в практику здравоохранения технологий диагностики и лечения заболеваний на основе персонализированной медицины.
Главное – это создание среды в которой будут генерироваться, создаваться, и использоваться новые технологии. Это формирование среды, где сможет осуществляться подготовка новых форматов врачей для будущей медицины.
Основными вопросами, которые будут рассматриваться в рамках нашего НЦМУ станут вопросы популяционной генетики, неинфекционных заболеваний, онкологии. Будут изучаться вопросы, связанные с поиском редких и даже неизвестных заболеваний механизмы развития, которых пока не известны.
Важнейшим направлением являются вопросы неинфекционных заболеваний – микробная, антимикробная терапия.
Все исследования спланированы в рамках единого трансляционного цикла, включающего инфраструктурные проекты и базовые исследования для создания клеточных, а также животных моделей, биоинформатических алгоритмов, платформ для тестирования лекарств, синтез различных конструкций. Также это проекты, результатами которых станут конкретные изменения в схемах и протоколах диагностики и лечения различных заболеваний – это схемы и персонализированной терапии, шкалы рисков, модели пациентов.
И наконец — заключительный этап, связанный с созданием и внедрением в практику продуктов — вакцин, препаратов, изделий медицинского назначения».

Целевая аудитория саммита — ведущие научные сотрудники НЦМУ, врачи государственных и частных медицинских учреждений, специалисты всех направлений медицины, студенты и молодые исследователи, организаторы здравоохранения, представители власти и бизнеса, общественные деятели и другие специалисты смежных областей.
Сотрудники НЦМУ «Центр персонализированной медицины» приняли активное участие в мероприятии, выступив с докладами в секциях «Онкология», «Инфекционные заболевания», «Кардиология», «Физиология – медицине».
Кроме того, специалисты были вовлечены в работу в формате круглых столов: «Цифровые экосистемы и искусственный интеллект в медицине», «Генетика и редкие заболевания» (модератор заместитель генерального директора по научной работе ФГБУ «НМИЦ им. В. А. Алмазова» Минздрава России, член-корреспондент РАН, профессор, д.м.н. Александра Олеговна Конради), «Генетика и редкие заболевания», «Эндокринология и патология метаболизма».
В Интеграционном саммите «Научные центры мирового уровня в сфере здравоохранения» приняли участие не только специалисты из России, но и зарубежные эксперты мирового уровня.
Читайте также:
Молодые ученые стали победителями конкурсов на Интеграционом саммите «Научные центры мирового уровня в сфере здравоохранения»